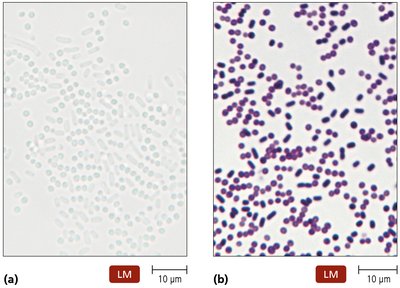
Comparison of stained and unstained cells under a light microscope

Back
BackMicroscopy, Staining, and Classification: Principles and Applications in Microbiology
Study Guide - Smart Notes

Microscopy, Staining, and Classification
Introduction to Microscopy
Microscopy is a foundational technique in microbiology, enabling the visualization of organisms and structures too small to be seen with the naked eye. The development and refinement of microscopes have allowed scientists to study the morphology, physiology, and classification of microorganisms.
Microscopy: The use of microscopes to magnify objects, making them visible for observation and analysis.
Essential for identifying and classifying microbes such as bacteria, protozoa, and fungi.

Basic Principles of Microscopy
Understanding microscopy requires familiarity with several key concepts: wavelength, magnification, resolution, and contrast.
Wavelengths of Radiation: The distance between two consecutive peaks of a wave. Shorter wavelengths provide higher resolving power, allowing finer details to be distinguished.
Magnification: The apparent increase in size of an object. Calculated as:
Resolution (Resolving Power): The ability to distinguish between two points that are close together. Higher resolution means finer detail can be observed.
Contrast: The difference in intensity between an object and its background. Staining and the use of phase-aligned light can enhance contrast.


Types of Microscopes
Several types of microscopes are used in microbiology, each with unique advantages and applications.
Light Microscopy
Bright Field Microscopes: Use visible light to illuminate specimens. Suitable for stained or naturally pigmented samples. Compound microscopes use a series of lenses for magnification and typically include a condenser to focus light.
Dark Field Microscopes: Enhance contrast in unstained, living specimens, making pale objects visible against a dark background.
Phase Microscopes: Allow observation of living, unstained cells by exploiting differences in refractive index. Includes phase-contrast and differential interference contrast (DIC) microscopes.
Fluorescence Microscopes: Use ultraviolet (UV) light to increase resolution and contrast. Some cells fluoresce naturally, while others are stained with fluorescent dyes. Widely used in immunofluorescence to identify pathogens.
Confocal Microscopes: Employ a UV laser to illuminate thin slices of a sample, producing high-resolution, three-dimensional images.

Electron Microscopy
Transmission Electron Microscopes (TEM): Use a beam of electrons transmitted through a specimen to reveal internal structures, such as organelles and viruses. Not suitable for living samples.
Scanning Electron Microscopes (SEM): Scan a specimen's surface with electrons, producing detailed, three-dimensional images of external structures. Not suitable for living samples.


Probe Microscopy
Scanning Tunneling Microscopes (STM): Use a sharp probe to scan the surface of a specimen at the atomic level, allowing visualization of individual molecules and atoms.
Atomic Force Microscopes (AFM): Similar to STM but can be used on non-conductive samples, providing topographical maps of surfaces at the nanometer scale.

Key Concepts and Applications
Resolution: The ability to distinguish between two adjacent points. Higher resolution is achieved with shorter wavelengths of radiation.
Magnification: Essential for observing microorganisms, but must be paired with adequate resolution to be useful.
Contrast: Enhanced by staining or specialized microscopy techniques, allowing better visualization of cellular structures.
Example: Bright field microscopy is commonly used to identify bacteria, while fluorescence microscopy is essential for detecting specific pathogens using labeled antibodies.
Summary Table: Types of Microscopes and Their Applications
Microscope Type | Sample Type | Key Features | Applications |
|---|---|---|---|
Bright Field | Stained or pigmented | General observation, 200 nm – 10 mm resolution | Microbe identification |
Dark Field | Unstained, living | High contrast for pale objects | Live cell observation |
Phase Contrast/DIC | Unstained, living | Enhanced contrast, 3D appearance | Live cell imaging |
Fluorescence | Fluorescently labeled | UV light, high contrast | Pathogen detection |
Confocal | Thick specimens | 3D imaging, thin slices | Biofilm studies |
SEM | Non-living, surface | 3D surface images | Surface morphology |
TEM | Non-living, thin sections | Internal structures | Ultrastructure analysis |
STM/AFM | Atomic/molecular | Atomic resolution | Nanoscale imaging |
Quiz Review and Key Points
Resolution is the ability to distinguish between two points that are close together.
Differential interference contrast microscopes produce 3D images with a shadowed appearance.
Shorter wavelengths correspond to higher resolving power (greater ability to distinguish fine details).
Additional info: Mastery of microscopy principles is essential for laboratory work in microbiology, as it underpins the identification, classification, and study of microorganisms.
